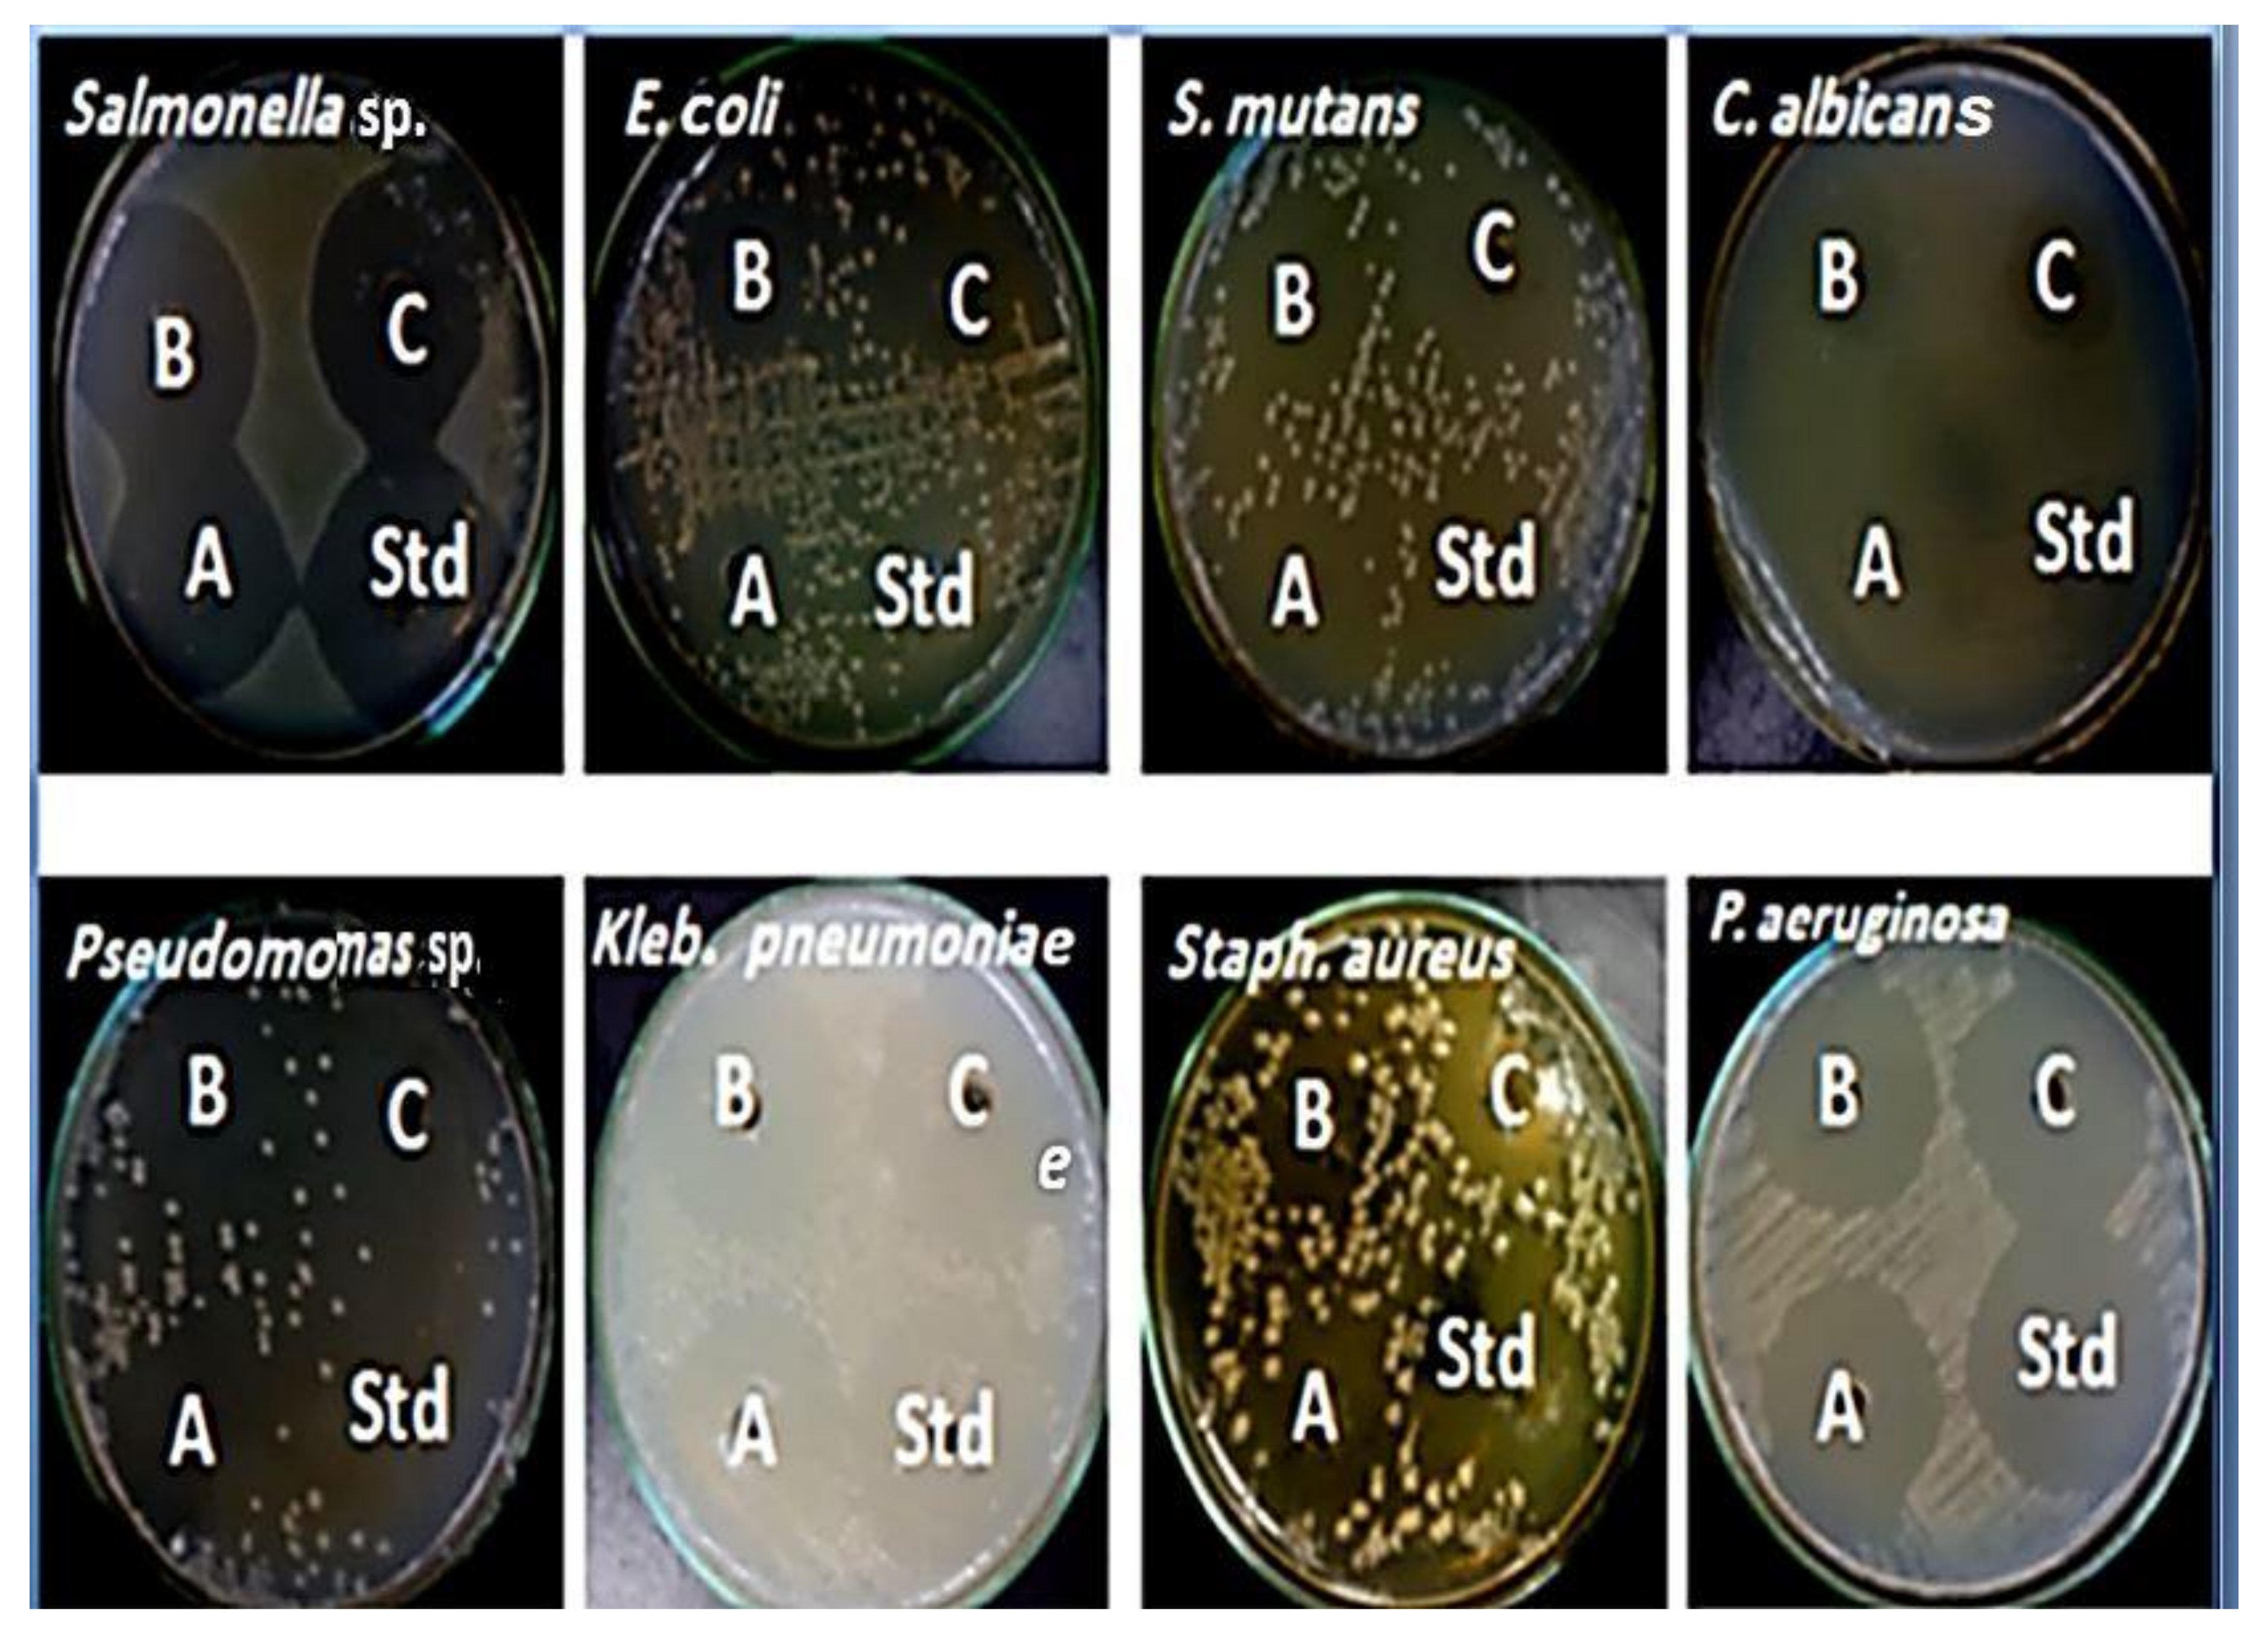
Molecules 27 02016 g003

Immunomodulatory Efficacy-Mediated Anti-HCV and Anti-HBV Potential of Kefir Grains; Unveiling the In Vitro Antibacterial, Antifungal, and Wound Healing Activities
Abstract
:1. Introduction
2. Results and Discussion
2.1. Quantification of Protein and Phenolic Contents
2.2. Quantification of Major Phenolic Compounds Using HPLC
2.3. Gas Chromatography/Mass Spectrometry Analysis (GC/MS) of Kefir Extract
2.4. Recognition of Kefir Antimicrobial Activity
2.5. Determination of Kefir Wound Healing Activity
2.6. Determination of Kefir Anti-HCV and Anti-HBV Activities
3. Materials and Methods
3.1. Chemicals and Reagents
3.2. Cultivation and Extraction of Milk Kefir
Kefir Production
3.3. Quantification of Protein and Phenolic Contents
Quantification of Major Phenolic Compounds Using HPLC
3.4. Gas Chromatography/Mass Spectrometry Analysis (GC/MS) of Kefir Extract
3.5. Recognition of Kefir Antimicrobial Activity
3.5.1. Test Organisms
3.5.2. Assay of Antibacterial Activity of Kefir
3.5.3. Assay of Kefir Antifungal Efficacy
3.6. Determination of Kefir Wound Healing Activity by Scratch Assay
3.7. Determination of anti-HCV and Anti-HBV Activities
3.7.1. Detection of Cytotoxicity of Milk Kefir Extracts against Viral Host Cells
3.7.2. Quantitative Detection of Anti-HCV and Anti-HBV Activities of Kefir Milk
3.7.3. Determination of Cytokine Levels in Kefir Extract-Treated Viral-Infected PBMCs
3.8. Statistical Analysis
4. Conclusions
Author Contributions
Funding
Institutional Review Board Statement
Informed Consent Statement
Data Availability Statement
Acknowledgments
Conflicts of Interest
Sample Availability
Ethical Approval
Abbreviations
| ALT | Alanine aminotransferase |
| AST | Aspartate aminotransferase |
| CREC | Carbapenem-resistant Enterobacter cloacae |
| HCV | Hepatitis C Virus |
| HBV | Hepatitis B Virus |
| HBsAg | HBV surface antigen |
| HBeAg | HBV core antigen |
| HBx | HBV pleiotropic regulatory protein X |
| GES-1: | Gastric epithelial cells |
| IL-10 | Interleukin-10 |
| LPS | Lipopolysaccharides |
| TNF-α | Tumor necrosis factor |
| INF-γ | Interferon-gamma |
| PBMCs | Peripheral blood mononuclear cells |
| FBS | Fetal bovine serum |
| qPCR | quantitative polymerase chain reaction |
| V.A | Vanillic acid |
| ZOI | Zone of Inhibition |
References
- de Simone, C. The Unregulated Probiotic Market. Clin. Gastroenterol. Hepatol. 2019, 17, 809–817. [Google Scholar] [CrossRef] [PubMed] [Green Version]
- Hong, W.S.; Chen, Y.P.; Chen, M.J. The Antiallergic Effect of Kefir Lactobacilli. J. Food Sci. 2010, 75, H244–H253. [Google Scholar] [CrossRef] [PubMed]
- Farag, M.A.; Jomaa, S.A.; El-wahed, A.A.; El-seedi, H.R. The Many Faces of Kefir Fermented Dairy Products: Quality Characteristics, Flavour Chemistry, Nutritional Value, Health Benefits, and Safety. Nutrients 2020, 12, 346. [Google Scholar] [CrossRef] [PubMed] [Green Version]
- Dailin, D.J.; Elsayed, E.A.; Malek, R.A.; Hanapi, S.Z.; Selvamani, S.; Ramli, S.; Sukmawati, D.; Sayyed, R.Z.; el Enshasy, H.A. Efficient Kefiran Production by Lactobacillus Kefiranofaciens ATCC 43761 in Submerged Cultivation: Influence of Osmotic Stress and Nonionic Surfactants, and Potential Bioactivities. Arab. J. Chem. 2020, 13, 8513–8523. [Google Scholar] [CrossRef]
- Terpou, A.; Papadaki, A.; Lappa, I.K.; Kachrimanidou, V.; Bosnea, L.A.; Kopsahelis, N. Probiotics in Food Systems: Significance and Emerging Strategies towards Improved Viability and Delivery of Enhanced Beneficial Value. Nutrients 2019, 11, 1591. [Google Scholar] [CrossRef] [Green Version]
- Angelidis, A.S.; Kalamaki, M.S.; Pexara, A.S.; Papageorgiou, D. Investigation of Staphylococcus aureus Growth and Enterotoxin Production during Artisanal Kefir Fermentation. LWT 2020, 134, 109956. [Google Scholar] [CrossRef]
- Guzel-Seydim, Z.B.; Kok-Tas, T.; Greene, A.K.; Seydim, A.C. Review: Functional Properties of Kefir. Crit. Rev. Food Sci. Nutr. 2011, 51, 261–268. [Google Scholar] [CrossRef]
- Stavropoulou, E.; Bezirtzoglou, E. Probiotics as a Weapon in the Fight Against COVID-19. Front. Nutr. 2020, 7, 614986. [Google Scholar] [CrossRef]
- Bhattacharya, R.; Gupta, A.M.; Mitra, S.; Mandal, S.; Biswas, S.R. A Natural Food Preservative Peptide Nisin Can Interact with the SARS-CoV-2 Spike Protein Receptor Human ACE2. Virology 2021, 552, 107–111. [Google Scholar] [CrossRef]
- Kim, D.H.; Jeong, D.; Kim, H.; Kang, I.B.; Chon, J.W.; Song, K.Y.; Seo, K.H. Antimicrobial Activity of Kefir against Various Food Pathogens and Spoilage Bacteria. Korean J. Food Sci. Anim. Resour. 2016, 36, 787–790. [Google Scholar] [CrossRef] [Green Version]
- Gaware, V.; Kotade, K.; Dolas, R.; Dhamak, K.; Somwanshi, S.; Nikam, V.; Khadse, A.; Kashid, V. The magic of kefir: A review. Pharmacologyonline 2011, 1, 376–386. [Google Scholar]
- Vinderoln, C.G.; Duarte, J.; Thangavev, D.; Perdigon, G.; Farnworth, E.; Matar, C.; Matar, C. Distal mucosal site stimulation by kefir and duration of the immune response. Eur. J. Inflamm. 2005, 3, 63–73. [Google Scholar] [CrossRef] [Green Version]
- Ulusoy, B.H.; Çolak, H.; Hampikyan, H.; Erkan, M.E. An in Vitro Study on the Antibacterial Effect of Kefir against Some Food-Borne Pathogens. Türk Mikrobiyoloji Cemiyeti Dergisi 2007, 37, 103–107. [Google Scholar]
- Enan, G.; Abdel-Haliem, M.E.; Tartour, E. Evaluation of the Antimicrobial Activity, Starter Capability and Technological Properties of Some Probiotic Bacteria Isolated from Egyptian Pickles. Life Sci. J. 2014, 11, 976–985. [Google Scholar]
- Miguel, M.G.D.C.P.; Cardoso, P.G.; de Assis Lago, L.; Schwan, R.F. Diversity of Bacteria Present in Milk Kefir Grains Using Culture-Dependent and Culture-Independent Methods. Food Res. Int. 2010, 43, 1523–1528. [Google Scholar] [CrossRef]
- Chen, H.L.; Hung, K.F.; Yen, C.C.; Laio, C.H.; Wang, J.L.; Lan, Y.W.; Chong, K.Y.; Fan, H.C.; Chen, C.M. Kefir Peptides Alleviate Particulate Matter <4 Μm (PM4.0)-Induced Pulmonary Inflammation by Inhibiting the NF-ΚB Pathway Using Luciferase Transgenic Mice. Sci. Rep. 2019, 9, 11529. [Google Scholar] [CrossRef]
- Wang, Y.; Ahmed, Z.; Feng, W.; Li, C.; Song, S. Physicochemical Properties of Exopolysaccharide Produced by Lactobacillus kefiranofaciens ZW3 Isolated from Tibet Kefir. Int. J. Biol. Macromol. 2008, 43, 283–288. [Google Scholar] [CrossRef]
- Serafini, F.; Turroni, F.; Ruas-Madiedo, P.; Lugli, G.A.; Milani, C.; Duranti, S.; Zamboni, N.; Bottacini, F.; van Sinderen, D.; Margolles, A.; et al. Kefir Fermented Milk and Kefiran Promote Growth of Bifidobacterium bifidum PRL2010 and Modulate Its Gene Expression. Int. J. Food Microbiol. 2014, 178, 50–59. [Google Scholar] [CrossRef]
- Rodrigues, K.L.; Carvalho, J.C.T.; Schneedorf, J.M. Anti-Inflammatory Properties of Kefir and Its Polysaccharide Extract. Inflammopharmacology 2005, 13, 485–492. [Google Scholar] [CrossRef]
- Chen, Z.; Shi, J.; Yang, X.; Nan, B.; Liu, Y.; Wang, Z. Chemical and Physical Characteristics and Antioxidant Activities of the Exopolysaccharide Produced by Tibetan Kefir Grains during Milk Fermentation. Int. Dairy J. 2015, 43, 15–21. [Google Scholar] [CrossRef]
- Palthur, M.P.; Palthur, S.S.S.; Chitta, S.K. Nutraceuticals: A Conceptual Definition. Int. J. Pharm. Pharm. Sci. 2010, 2, 19–27. [Google Scholar]
- Prado, M.R.; Blandón, L.M.; Vandenberghe, L.P.S.; Rodrigues, C.; Castro, G.R.; Thomaz-Soccol, V.; Soccol, C.R. Milk Kefir: Composition, Microbial Cultures, Biological Activities, and Related Products. Front. Microbiol. 2015, 6, 1177. [Google Scholar] [CrossRef] [PubMed] [Green Version]
- Al-Mohammadi, A.R.; Ibrahim, R.A.; Moustafa, A.H.; Ismaiel, A.A.; Abou Zeid, A.; Enan, G. Chemical Constitution and Antimicrobial Activity of Kefir Fermented Beverage. Molecules 2021, 26, 2635. [Google Scholar] [CrossRef] [PubMed]
- Abd Ellatif, S.A.A.; Bouqellah, N.A.; Abu-Serie, M.M.; Razik, E.S.A.; L-surhanee, A.A.A.; el Askary, A.; Daigham, G.E.; Mahfouz, A.Y. Assessment of Probiotic Efficacy and Anticancer Activities of Lactiplantibacillus plantarum ESSG1 (MZ683194.1) and Lactiplantibacillus pentosus ESSG2 (MZ683195.1) Isolated from Dairy Products. Environ. Sci. Pollut. Res. 2022, 1, 1–18. [Google Scholar] [CrossRef] [PubMed]
- Lin, D.; Xiao, M.; Zhao, J.; Li, Z.; Xing, B.; Li, X.; Kong, M.; Li, L.; Zhang, Q.; Liu, Y.; et al. An Overview of Plant Phenolic Compounds and Their Importance in Human Nutrition and Management of Type 2 Diabetes. Molecules 2016, 21, 1374. [Google Scholar] [CrossRef]
- Calland, N.; Sahuc, M.-E.; Belouzard, S.; Pène, V.; Bonnafous, P.; Mesalam, A.A.; Deloison, G.; Descamps, V.; Sahpaz, S.; Wychowski, C.; et al. Polyphenols Inhibit Hepatitis C Virus Entry by a New Mechanism of Action. J. Virol. 2015, 89, 10053–10063. [Google Scholar] [CrossRef] [Green Version]
- Habashy, N.H.; Abu-Serie, M.M. Major Royal-Jelly Protein 2 and Its Isoform X1 Are Two Novel Safe Inhibitors for Hepatitis C and B Viral Entry and Replication. Int. J. Biol. Macromol. 2019, 141, 1072–1087. [Google Scholar] [CrossRef]
- Othman, L.; Sleiman, A.; Abdel-Massih, R.M. Antimicrobial Activity of Polyphenols and Alkaloids in Middle Eastern Plants. Front. Microbiol. 2019, 10, 911. [Google Scholar] [CrossRef]
- Chojnacka, K.; Skrzypczak, D.; Izydorczyk, G.; Witek-Krowiak, A.; Mikula, K.; Szopa, D. Antiviral Properties of Polyphenols from Plants. Foods 2021, 10, 2277. [Google Scholar] [CrossRef]
- Guimarães, I.; Baptista-Silva, S.; Pintado, M.; Oliveira, A.L. Polyphenols: A Promising Avenue in Therapeutic Solutions for Wound Care. Appl. Sci. 2021, 11, 1230. [Google Scholar] [CrossRef]
- Acerbi, G.; Montali, I.; Ferrigno, G.D.; Barili, V.; Schivazappa, S.; Alfieri, A.; Laccabue, D.; Loglio, A.; Borghi, M.; Massari, M.; et al. Functional Reconstitution of HBV-Specific CD8 T Cells by in Vitro Polyphenol Treatment in Chronic Hepatitis B. J. Hepatol. 2021, 74, 783–793. [Google Scholar] [CrossRef] [PubMed]
- Govea-Salas, M.; Rivas-Estilla, A.M.; Rodríguez-Herrera, R.; Lozano-Sepúlveda, S.A.; Aguilar-Gonzalez, C.N.; Zugasti-Cruz, A.; Salas-Villalobos, T.B.; Morlett-Chávez, J.A. Gallic Acid Decreases Hepatitis C Virus Expression through Its Antioxidant Capacity. Exp. Ther. Med. 2016, 11, 619–624. [Google Scholar] [CrossRef] [PubMed] [Green Version]
- Bai, J.; Zhang, Y.; Tang, C.; Hou, Y.; Ai, X.; Chen, X.; Zhang, Y.; Wang, X.; Meng, X. Gallic Acid: Pharmacological Activities and Molecular Mechanisms Involved in Inflammation-Related Diseases. Biomed. Pharmacother. 2021, 133, 110985. [Google Scholar] [CrossRef] [PubMed]
- Kakkar, S.; Bais, S. A Review on Protocatechuic Acid and Its Pharmacological Potential. ISRN Pharmacol. 2014, 2014, 1–9. [Google Scholar] [CrossRef] [Green Version]
- Dai, X.Q.; Cai, W.T.; Wu, X.; Chen, Y.; Han, F.M. Protocatechuic Acid Inhibits Hepatitis B Virus Replication by Activating ERK1/2 Pathway and down-Regulating HNF4α and HNF1α in Vitro. Life Sci. 2017, 180, 68–74. [Google Scholar] [CrossRef]
- Guo, Y.; Zhang, Q.; Zuo, Z.; Chu, J.; Xiao, H.; Javed, M.T.; He, C. Protocatechuic Acid (PCA) Induced a Better Antiviral Effect by Immune Enhancement in SPF Chickens. Microb. Pathog. 2018, 114, 233–238. [Google Scholar] [CrossRef]
- Ullah, R.; Ikram, M.; Park, T.J.; Ahmad, R.; Saeed, K.; Alam, S.I.; Rehman, I.U.; Khan, A.; Khan, I.; Jo, M.G.; et al. Vanillic Acid, a Bioactive Phenolic Compound, Counteracts LPS-Induced Neurotoxicity by Regulating c-Jun N-Terminal Kinase in Mouse Brain. Int. J. Mol. Sci. 2020, 22, 361. [Google Scholar] [CrossRef]
- Singh, J.C.H.; Kakalij, R.M.; Kshirsagar, R.P.; Kumar, B.H.; Komakula, S.S.B.; Diwan, P.V. Cognitive Effects of Vanillic Acid against Streptozotocin-Induced Neurodegeneration in Mice. Pharm. Biol. 2015, 53, 630–636. [Google Scholar] [CrossRef] [Green Version]
- Calixto-Campos, C.; Carvalho, T.T.; Hohmann, M.S.N.; Pinho-Ribeiro, F.A.; Fattori, V.; Manchope, M.F.; Zarpelon, A.C.; Baracat, M.M.; Georgetti, S.R.; Casagrande, R.; et al. Vanillic Acid Inhibits Inflammatory Pain by Inhibiting Neutrophil Recruitment, Oxidative Stress, Cytokine Production, and NFκB Activation in Mice. J. Nat. Prod. 2015, 78, 1799–1808. [Google Scholar] [CrossRef]
- Salau, V.F.; Erukainure, O.L.; Ibeji, C.U.; Olasehinde, T.A.; Koorbanally, N.A.; Islam, M.S. Vanillin and Vanillic Acid Modulate Antioxidant Defense System via Amelioration of Metabolic Complications Linked to Fe2+-Induced Brain Tissues Damage. Metab. Brain Dis. 2020, 35, 727–738. [Google Scholar] [CrossRef]
- Ul Amin, F.; Shah, S.A.; Kim, M.O. Vanillic Acid Attenuates Aβ1-42-Induced Oxidative Stress and Cognitive Impairment in Mice. Sci. Rep. 2017, 7, 40753. [Google Scholar] [CrossRef]
- Sun, Y.; Gong, X.; Tan, J.Y.; Kang, L.; Li, D.; Vikash; Yang, J.; Du, G. In Vitro Antiviral Activity of Rubia cordifolia Aerial Part Extract against Rotavirus. Front. Pharmacol. 2016, 7, 308. [Google Scholar] [CrossRef] [PubMed] [Green Version]
- Huang, S.X.; Mou, J.F.; Luo, Q.; Mo, Q.H.; Zhou, X.L.; Huang, X.; Xu, Q.; Tan, X.D.; Chen, X.; Liang, C.Q. Anti-Hepatitis B Virus Activity of Esculetin from Microsorium fortunei In Vitro and In Vivo. Molecules 2019, 24, 3475. [Google Scholar] [CrossRef] [Green Version]
- Takeuchi, F.; Ikeda, S.; Tsukamoto, Y.; Iwasawa, Y.; Qihao, C.; Otakaki, Y.; Ryota, O.; Yao, W.L.; Narita, R.; Makoto, H.; et al. Screening for Inhibitor of Episomal DNA Identified Dicumarol as a Hepatitis B Virus Inhibitor. PLoS ONE 2019, 14, e0212233. [Google Scholar] [CrossRef]
- Kumar, S. A Brief Review of the Biological Potential of Indole Derivatives. Future J. Pharm. Sci. 2020, 6, 1–19. [Google Scholar] [CrossRef]
- Harada, H.; Yamashita, U.; Kurihara, H.; Fukushi, E.; Kawabata, J.; Kamei, Y. Antitumor Activity of Palmitic Acid Found as a Selective Cytotoxic Substance in a Marine Red Alga. Anicancer Res. 2002, 22, 2587–2590. [Google Scholar]
- Vieira, C.P.; Álvares, T.S.; Gomes, L.S.; Torres, A.G.; Paschoalin, V.M.F.; Conte, C.A. Kefir Grains Change Fatty Acid Profile of Milk during Fermentation and Storage. PLoS ONE 2015, 10, e0139910. [Google Scholar] [CrossRef]
- Zhao, L.; Zhang, H.; Hao, T.; Li, S. In Vitro Antibacterial Activities and Mechanism of Sugar Fatty Acid Esters against Five Food-Related Bacteria. Food Chem. 2015, 187, 370–377. [Google Scholar] [CrossRef]
- Fukuzawa, M.; Yamaguchi, R.; Hide, I.; Chen, Z.; Hirai, Y.; Sugimoto, A.; Yasuhara, T.; Nakata, Y. Possible Involvement of Long Chain Fatty Acids in the Spores of Ganoderma lucidum (Reishi Houshi) to Its Anti-Tumor Activity. Biol. Pharm. Bull. 2008, 31, 1933–1937. [Google Scholar] [CrossRef] [Green Version]
- Kanthal, L.K.; Dey, A.; Satyavathi, K.; Bhojaraju, P. GC-MS Analysis of Bio-Active Compounds in Methanolic Extract of Lactuca runcinata DC. Pharmacogn. Res. 2014, 6, 58–61. [Google Scholar] [CrossRef] [PubMed] [Green Version]
- Pushpa Rani, K.T. Phytochemical Screening and GC-MS Analysis of Leaf Extract of Pergularia daemia (Forssk) Chiov. Pelagia Res. Libr. Asian J. Plant Sci. Res. 2017, 7, 9–15. [Google Scholar]
- Farina Asghar, S.; Choudahry, M.I.; Ebrahim Jamal, H. Gas Chromatography-Mass Spectrometry (GC-MS) Analysis of Petroleum Ether Extract (Oil) and Bio-Assays of Crude Extract of Iris Germanica. Int. J. Genet. Mol. Biol. 2011, 3, 95–100. [Google Scholar]
- Chandrasekaran, M.; Senthilkumar, A.; Venkatesalu, V. Antibacterial and Antifungal Efficacy of Fatty Acid Methyl Esters from the Leaves of Sesuvium portulacastrum L. Eur. Rev. Med. Pharmacol. Sci. 2011, 15, 775–780. [Google Scholar]
- Vanitha, V.; Vijayakumar, S.; Nilavukkarasi, M.; Punitha, V.N.; Vidhya, E.; Praseetha, P.K. Heneicosane—A Novel Microbicidal Bioactive Alkane Identified from Plumbago zeylanica L. Ind. Crops Prod. 2020, 154, 112748. [Google Scholar] [CrossRef]
- Karanja, E.N.; Boga, H.I.; Muigai, A.W.; Wamunyokoli, F.; Kinyua, J.; Nonoh, J.O. Growth characteristics and production of secondary metabolites from selected novel Streptomyces species isolated from selected kenyan national parks. JKUAT Annu. Sci. Conf. Proc. 2012. [Google Scholar]
- Usha, N.S.; Sangareshwari, S.; Kumari, L. Gas Chromatography-mass spectrometry analysis of bioactive constituents from the marine Streptomyces. Asian J. Pharm. Clin. Res. 2015, 8, 244–246. [Google Scholar]
- Krishnamoorthy, K.; Subramaniam, P. Phytochemical Profiling of Leaf, Stem, and Tuber Parts of Solena amplexicaulis (Lam.) Gandhi Using GC-MS. Int. Sch. Res. Not. 2014, 2014, 567409. [Google Scholar] [CrossRef] [Green Version]
- Pinto, M.E.A.; Araújo, S.G.; Morais, M.I.; SÁ, N.P.; Lima, C.M.; Rosa, C.A.; SIqueira, E.P.; Johann, S.; LIMA, L.A.R.S. Antifungal and Antioxidant Activity of Fatty Acid Methyl Esters from Vegetable Oils. An. Acad. Bras. Ciências 2017, 89, 1671–1681. [Google Scholar] [CrossRef] [Green Version]
- Rahuman, A.A.; Gopalakrishnan, G.; Ghouse, B.S.; Arumugam, S.; Himalayan, B. Effect of Feronia Limonia on Mosquito Larvae. Fitoterapia 2000, 71, 553–555. [Google Scholar] [CrossRef]
- Bakr, R.O.; El-Naa, M.M.; Zaghloul, S.S.; Omar, M.M. Profile of Bioactive Compounds in Nymphaea alba L. Leaves Growing in Egypt: Hepatoprotective, Antioxidant and Anti-Inflammatory Activity. BMC Complementary Altern. Med. 2017, 17, 52. [Google Scholar] [CrossRef] [PubMed] [Green Version]
- Mahmood, A.; Ahmed, R.; Kosar, S. Phytochemical Screening and Biological Activities of the Oil Components of Prunus domestica Linn. J. Saudi Chem. Soc. 2009, 13, 273–277. [Google Scholar] [CrossRef] [Green Version]
- Roy, R.N.; Laskar, S.; Sen, S.K. Dibutyl Phthalate, the Bioactive Compound Produced by Streptomyces albidoflavus 321.2. Microbiol. Res. 2006, 161, 121–126. [Google Scholar] [CrossRef] [PubMed]
- Wei, C.C.; Yen, P.L.; Chang, S.T.; Cheng, P.L.; Lo, Y.C.; Liao, V.H.C. Antioxidative Activities of Both Oleic Acid and Camellia tenuifolia Seed Oil Are Regulated by the Transcription Factor DAF-16/FOXO in Caenorhabditis Elegans. PLoS ONE 2016, 11, e0157195. [Google Scholar] [CrossRef] [PubMed] [Green Version]
- He, Y.L.; Huang, S.S.; Deng, J.S.; Lin, Y.H.; Chang, Y.S.; Huang, G.J. In Vitro Antioxidant Properties and Total Phenolic Contents of Wetland Medicinal Plants in Taiwan. Bot. Stud. 2012, 53, 55–66. [Google Scholar]
- Jegadeeswari, P.; Nishanthini, A.; Muthukumarasamy, S.M.V.R.; Mohan, V.R. GC-MS Analysis of Bioactive Components of Aristolochia krysagathra (Aristolochiaceae). J. Curr. Chem. Pharm. Sci. 2012, 2, 226–232. [Google Scholar]
- Plessas, S.; Nouska, C.; Mantzourani, I.; Kourkoutas, Y.; Alexopoulos, A.; Bezirtzoglou, E. Microbiological Exploration of Different Types of Kefir Grains. Fermentation 2017, 3, 1. [Google Scholar] [CrossRef] [Green Version]
- Paulo, J.; Santos, V.; Ferreira Araújo, T.; Lúcia De Luces, C.; Ferreira, F.; Goulart, S.M. Brazilian archives of biology and technology Evaluation of Antagonistic Activity of Milk Fermented with Kefir Grains of Different Origins. Arch. Biol. Technol. 2013, 56, 823–827. [Google Scholar]
- Sindi, A.; Badsha, M.B.; Nielsen, B.; Ünlü, G. Antimicrobial Activity of Six International Artisanal Kefirs against Bacillus cereus, Listeria monocytogenes, Salmonella enterica, Serovar enteritidis and Staphylococcus aureus. Microorganisms 2020, 8, 849. [Google Scholar] [CrossRef]
- de Lima, M.d.S.F.; da Silva, R.A.; da Silva, M.F.; da Silva, P.A.B.; Costa, R.M.P.B.; Teixeira, J.A.C.; Porto, A.L.F.; Cavalcanti, M.T.H. Brazilian Kefir-Fermented Sheep’s Milk, a Source of Antimicrobial and Antioxidant Peptides. Probiotics Antimicrob. Proteins 2018, 10, 446–455. [Google Scholar] [CrossRef] [Green Version]
- Namaei, M.H.; Ghannadkafi, M.; Ziaee, M. Antibacterial Effect of Non-Industrial Yogurt on Salmonella and Shigella. Mod. Care J. 2015, 12, 109–113. [Google Scholar]
- Londero, A.; León Peláez, M.A.; Diosma, G.; de Antoni, G.L.; Abraham, A.G.; Garrote, G.L. Fermented Whey as Poultry Feed Additive to Prevent Fungal Contamination. J. Sci. Food Agric. 2014, 94, 3189–3194. [Google Scholar] [CrossRef] [PubMed]
- Gamba, R.R.; Caro, C.A.; Martínez, O.L.; Moretti, A.F.; Giannuzzi, L.; de Antoni, G.L.; León Peláez, A. Antifungal Effect of Kefir Fermented Milk and Shelf Life Improvement of Corn Arepas. Int. J. Food Microbiol. 2016, 235, 85–92. [Google Scholar] [CrossRef] [PubMed] [Green Version]
- ben Taheur, F.; Chalbia, M.; Chaieb, K. Inhibitory Effect of Kefir on Aspergillus Growth and Mycotoxin Production. Euro-Mediterr. J. Environ. Integr. 2020, 5, 1–8. [Google Scholar] [CrossRef]
- Zhang, M.; Li, H.; Ma, H.; Qin, J. A Simple Microfluidic Strategy for Cell Migration Assay in an in Vitro Wound-Healing Model. Wound Repair Regen. 2013, 21, 897–903. [Google Scholar] [CrossRef]
- Cai, A.Q.; Landman, K.A.; Hughes, B.D. Multi-Scale Modeling of a Wound-Healing Cell Migration Assay. J. Theor. Biol. 2007, 245, 576–594. [Google Scholar] [CrossRef]
- Knackstedt, R.; Knackstedt, T.; Gatherwright, J. The Role of Topical Probiotics on Wound Healing: A Review of Animal and Human Studies. Int. Wound J. 2020, 17, 1687–1694. [Google Scholar] [CrossRef]
- Huseini, H.F.; Rahimzadeh, G.; Fazeli, M.R.; Mehrazma, M.; Salehi, M. Evaluation of Wound Healing Activities of Kefir Products. Burns 2012, 38, 719–723. [Google Scholar] [CrossRef]
- Kouyoumjian, S.P.; Chemaitelly, H.; Abu-Raddad, L.J. Characterizing Hepatitis C Virus Epidemiology in Egypt: Systematic Reviews, Meta-Analyses, and Meta-Regressions OPEN. Sci. Rep. 2018, 8, 1661. [Google Scholar] [CrossRef]
- WHO. Global Progress Report on HIV, Viral Hepatitis and Sexually Transmitted Infections; WHO: Geneva, Switzerland, 2021. [Google Scholar]
- Fooladi, A.A.I.; Hosseini, H.M.; Nourani, M.R.; Khani, S.; Alavian, S.M. Probiotic as a Novel Treatment Strategy against Liver Disease. Hepat. Mon. 2013, 13, e7521. [Google Scholar] [CrossRef] [Green Version]
- Jorgovanovic, D.; Song, M.; Wang, L.; Zhang, Y. Roles of IFN-γ in Tumor Progression and Regression: A Review. Biomark. Res. 2020, 8, 49. [Google Scholar] [CrossRef] [PubMed]
- Mendoza, J.L.; Escalante, N.K.; Jude, K.M.; Sotolongo Bellon, J.; Su, L.; Horton, T.M.; Tsutsumi, N.; Berardinelli, S.J.; Haltiwanger, R.S.; Piehler, J.; et al. Structure of the IFNγ Receptor Complex Guides Design of Biased Agonists. Nature 2019, 567, 56–60. [Google Scholar] [CrossRef] [PubMed]
- Ivashkiv, L.B. IFNγ: Signalling, Epigenetics and Roles in Immunity, Metabolism, Disease and Cancer Immunotherapy. Nat. Rev. Immunol. 2018, 18, 545–558. [Google Scholar] [CrossRef] [PubMed]
- Umlauf, B.J.; Ovsyannikova, I.G.; Haralambieva, I.H.; Kennedy, R.B.; Vierkant, R.A.; Pankratz, V.S.; Jacobson, R.M.; Poland, G.A. Correlations between Vaccinia-Specific Immune Responses within a Cohort of Armed Forces Members. Viral Immunol. 2011, 24, 415–420. [Google Scholar] [CrossRef] [PubMed] [Green Version]
- de Oliveira, D.M. Influence of a Kefir-Derived Antimicrobial Fraction on Zika Virus Cytopathic Effects and Lymphocyte Proliferation. Juniper Online J. Immuno Virol. 2017, 2, 555584. [Google Scholar] [CrossRef]
- Carasi, P.; Racedo, S.M.; Jacquot, C.; Romanin, D.E.; Serradell, M.A.; Urdaci, M.C. Impact of Kefir Derived Lactobacillus kefiri on the Mucosal Immune Response and Gut Microbiota. J. Immunol. Res. 2015, 2015, 361604. [Google Scholar] [CrossRef] [PubMed] [Green Version]
- Chen, Y.P.; Hsiao, P.J.; Hong, W.S.; Dai, T.Y.; Chen, M.J. Lactobacillus kefiranofaciens M1 Isolated from Milk Kefir Grains Ameliorates Experimental Colitis in Vitro and in Vivo. J. Dairy Sci. 2012, 95, 63–74. [Google Scholar] [CrossRef] [Green Version]
- Zamberi, N.R.; Abu, N.; Mohamed, N.E.; Nordin, N.; Keong, Y.S.; Beh, B.K.; Zakaria, Z.A.B.; Nik Abdul Rahman, N.M.A.; Alitheen, N.B. The Antimetastatic and Antiangiogenesis Effects of Kefir Water on Murine Breast Cancer Cells. Integr. Cancer Ther. 2016, 15, NP53–NP66. [Google Scholar] [CrossRef]
- Hamida, R.S.; Shami, A.; Ali, M.A.; Almohawes, Z.N.; Mohammed, A.E.; Bin-Meferij, M.M. Kefir: A Protective Dietary Supplementation against Viral Infection. Biomed. Pharmacother. 2021, 133, 110974. [Google Scholar] [CrossRef]
- Chen, M.J.; Liu, J.R.; Sheu, J.F.; Lin, C.W.; Chuang, C.L. Study on Skin Care Properties of Milk Kefir Whey. Asian-Australas. J. Anim. Sci. 2006, 19, 905–908. [Google Scholar] [CrossRef]
- Bradford, M.M. A Rapid and Sensitive Method for the Quantitation of Microgram Quantities of Protein Utilizing the Principle of Protein-Dye Binding. Anal. Biochem. 1976, 72, 248–254. [Google Scholar] [CrossRef]
- Gini, T.G.; Jeya Jothi, G. Column Chromatography and HPLC Analysis of Phenolic Compounds in the Fractions of Salvinia Molesta Mitchell. Egypt. J. Basic Appl. Sci. 2018, 5, 197–203. [Google Scholar] [CrossRef] [Green Version]
- Elshafie, H.S.; Mancini, E.; Sakr, S.; de Martino, L.; Mattia, C.A.; de Feo, V.; Camele, I. Antifungal Activity of Some Constituents of Origanum vulgare L. Essential Oil Against Postharvest Disease of Peach Fruit. J. Med. Food 2015, 18, 929–934. [Google Scholar] [CrossRef] [PubMed]
- Azizkhani, M.; Saris, P.E.J.; Baniasadi, M. An In-Vitro Assessment of Antifungal and Antibacterial Activity of Cow, Camel, Ewe, and Goat Milk Kefir and Probiotic Yogurt. J. Food Meas. Charact. 2021, 15, 406–415. [Google Scholar] [CrossRef]
- Eddine, S.D.; Yasmine, S.; Fatima, G.; Amina, Z.; Battache, G.; Mebrouk, K. Antifungal and Antibacterial Activity of Some Lactobacilli Isolated from Camel’s Milk Biotope in the South of Algeria. J. Microbiol. Biotechnol. Food Sci. 2018, 8, 871–877. [Google Scholar] [CrossRef]
- Fushimi, T.; Inui, S.; Nakajima, T.; Ogasawara, M.; Hosokawa, K.; Itami, S. Green Light Emitting Diodes Accelerate Wound Healing: Characterization of the Effect and Its Molecular Basis in Vitro and in Vivo. Wound Repair Regen. 2012, 20, 226–235. [Google Scholar] [CrossRef]
- Cormier, N.; Yeo, A.; Fiorentino, E.; Paxson, J. Optimization of the Wound Scratch Assay to Detect Changes in Murine Mesenchymal Stromal Cell Migration After Damage by Soluble Cigarette Smoke Extract. J. Vis. Exp. JoVE 2015, 3, e53414. [Google Scholar] [CrossRef] [Green Version]
- Mosmann, T. Rapid Colorimetric Assay for Cellular Growth and Survival: Application to Proliferation and Cytotoxicity Assays. J. Immunol. Methods 1983, 65, 55–63. [Google Scholar] [CrossRef]
- Mandour, M.; Nemr, N.; Shehata, A.; Kishk, R.; Badran, D.; Hawass, N. Occult HBV Infection Status among Chronic Hepatitis C and Hemodialysis Patients in Northeastern Egypt: Regional and National Overview. Rev. Soc. Bras. Med. Trop. 2015, 48, 258–264. [Google Scholar] [CrossRef] [Green Version]

| Sample | Active Components | Peak Area | Conc. (µg/mL) | Retention Time | Units |
|---|---|---|---|---|---|
| Kefir | Gallic Acid | 6.048 | 8.6543 ± 0.00321 | 3.038 | µg/mL |
| Protocatechuic Acid | 8.20 | 10.849 ± 0.00153 | 3.512 | µg/mL | |
| Esculatin | 9.719 | 2.545 ± 0.00265 | 4.820 | µg/mL | |
| Vanillic Acid | 5.54 | 1.066 ± 0.01000 | 5.069 | µg/mL | |
| Coumarin | 2.41 | 1.390 ± 0.01000 | 11.715 | µg/mL | |
| 4,3-Indole Butyl Acetic Acid | 9.527 | 3.240 ± 0.02000 | 14.936 | µg/mL |
| ID | Name | R. Time | Base Beak (m/z) | Area | Height | Mol. Formula and mol. wt. | Ret. Index | Reported Bioactivity |
|---|---|---|---|---|---|---|---|---|
| 1 | Hexadecanoic acid methyl ester | 15.093 | 74.00 | 620,892 | 168431 | C17H34O2 (270) | 1878 | Antioxidant, decrease blood cholesterol, anti-inflammatory [52]. |
| 2 | n-Hexadecanoic acid | 15.525 | 43.00 | 3,772,458 | 956337 | C16H32O2 (256) | 1968 | Antibacterial and antifungal [53] |
| 3 | Heneicosane | 15.998 | 57.00 | 397,344 | 75000 | C21H44 (296) | 2109 | Microbicide activities [54] |
| 4 | Hexadecane, 2,6,10,14-tetramethyl | 16.259 | 57.00 | 430,571 | 96464 | C20H42 (282) | 1753 | Antifungal compound [55,56] |
| 5 | 9-Octadecenoic acid methyl ester (E)- | 16.542 | 55.00 | 1,989,019 | 523430 | C19H36O2 (296) | 2085 | Anti-inflammatory, antiandrogenic, cancer preventive, dermatitigenic, irritant, anti-leukotriene—D4, hypocholesterolemic, 5-alpha reductase inhibitor, anemia genic, insectifuge, flavor [57] |
| 6 | Octadecanoic acid methyl ester | 16.735 | 74.00 | 578,657 | 233210 | C19H38O2 (298) | 2077 | Antifungal and antioxidant [58] |
| 7 | cis-10-Heptadecenoic acid | 17.122 | 55.00 | 11,457,870 | 1249206 | C17H32O2 (268) | 2075 | - |
| 8 | Octadecanoic acid | 17.225 | 43.00 | 1,259,058 | 393863 | C18H36O2 (284) | 2167 | Antimicrobial activity [59] |
| 9 | Octacosane | 17.417 | 57.00 | 216,706 | 95749 | C28H58 (394) | 2804 | Potent antioxidant and anti-inflammatory [60] |
| 10 | Eicosane | 17.517 | 57.00 | 257,731 | 77585 | C20H42 (282) | 2009 | Antifungal activity [55,56] |
| 11 | Pentadecane, 8-hexyl- | 17.809 | 57.00 | 423,598 | 114954 | C21H44 (296) | 2045 | Microbicide activities [54] |
| 12 | Triacontane | 20.132 | 57.00 | 417,739 | 87195 | C34H70 (478) | 3401 | Antibacterial and Antifungal [61] |
| 13 | 1,2-Benzenedicarboxylic acid, mono(2-ethylhexyl) ester | 23.290 | 149.00 | 901,111 | 192559 | C16H22O4 (278) | 2162 | antifungal compound [56,62] |
| 14 | 9-Octadecenoic acid (Z)-, 2,3-dihydroxy propyl ester | 27.527 | 55.00 | 954,576 | 81922 | C21H40O4 (356) | 2689 | Antioxidant [63,64] anti-inflammatory insecticides [28,65] |
| Treatments | Conc. | Salmonella sp. | E. coli | Streptococcus mutans | Candida albicans | Pseudomonas sp. | Klebsiella Pneumoniae | Staphylococcus aureus | Pseudomonas aeruginosa |
|---|---|---|---|---|---|---|---|---|---|
| ZOI (mm) | |||||||||
| Kefir | 40 µg/mL | 30.85 ± 0.21 | 23.7 ± 0.14 | 28.6 ± 0.2 | 15.7 ± 0.21 | 32.65 ± 0.27 | 36.8 ± 0.17 | 27.4 ± 0.33 | 18.6 ± 0.12 |
| 50 µg/mL | 32.25 ± 0.44 | 25.6 ± 0.19 | 32.3 ± 0.15 | 20.2 ± 0.11 | 35.35 ± 0.21 | 38.7 ± 0.22 | 31.2 ± 0.18 | 20.5 ± 0.22 | |
| 60 µg/mL | 33.11 ± 0.24 | 33.4 ± 0.32 | 35.1 ± 0.24 | 23.25 ± 0.25 | 39.7 ± 0.28 | 43.25 ± 0.31 | 32.6 ± 0.32 | 32.6 ± 0.31 | |
| 10 µg/mL Ampicillin (Control) | 10 µg/mL | 37.15 ± 0.28 | 27.5 ± 0. 5 | 28.9 ± 0.37 | 25.85 ± 0.25 | 32.85 ± 0.18 | 37.55 ± 0.18 | 36.1 ± 0.29 | 26.81 ± 0.3 |
| Fungal Strains | Growth Inhibition % |
|---|---|
| Aspergillus flavus AUMC 13922 | 80 ± 0.21 |
| Aspergillus fumigatus | 80 ± 0.7 |
| Aspergillus brasiliensis AUMC 13921 | 75 ± 0.28 |
| Penicillium expansum | 87 ± 0.50 |
Publisher’s Note: MDPI stays neutral with regard to jurisdictional claims in published maps and institutional affiliations. |
© 2022 by the authors. Licensee MDPI, Basel, Switzerland. This article is an open access article distributed under the terms and conditions of the Creative Commons Attribution (CC BY) license (https://creativecommons.org/licenses/by/4.0/).
Share and Cite
Ellatif, S.A.; Abdel Razik, E.S.; Abu-Serie, M.M.; Mahfouz, A.; Shater, A.F.; Saleh, F.M.; Hassan, M.M.; Alsanie, W.F.; Altalhi, A.; Daigham, G.E.; et al. Immunomodulatory Efficacy-Mediated Anti-HCV and Anti-HBV Potential of Kefir Grains; Unveiling the In Vitro Antibacterial, Antifungal, and Wound Healing Activities. Molecules 2022, 27, 2016. https://doi.org/10.3390/molecules27062016
Ellatif SA, Abdel Razik ES, Abu-Serie MM, Mahfouz A, Shater AF, Saleh FM, Hassan MM, Alsanie WF, Altalhi A, Daigham GE, et al. Immunomodulatory Efficacy-Mediated Anti-HCV and Anti-HBV Potential of Kefir Grains; Unveiling the In Vitro Antibacterial, Antifungal, and Wound Healing Activities. Molecules. 2022; 27(6):2016. https://doi.org/10.3390/molecules27062016
Chicago/Turabian StyleEllatif, Sawsan Abd, Elsayed S. Abdel Razik, Marwa M. Abu-Serie, Ahmed Mahfouz, Abdullah F. Shater, Fayez M. Saleh, Mohamed M. Hassan, Walaa F. Alsanie, Abdullah Altalhi, Ghadir E. Daigham, and et al. 2022. "Immunomodulatory Efficacy-Mediated Anti-HCV and Anti-HBV Potential of Kefir Grains; Unveiling the In Vitro Antibacterial, Antifungal, and Wound Healing Activities" Molecules 27, no. 6: 2016. https://doi.org/10.3390/molecules27062016
APA StyleEllatif, S. A., Abdel Razik, E. S., Abu-Serie, M. M., Mahfouz, A., Shater, A. F., Saleh, F. M., Hassan, M. M., Alsanie, W. F., Altalhi, A., Daigham, G. E., & Mahfouz, A. Y. (2022). Immunomodulatory Efficacy-Mediated Anti-HCV and Anti-HBV Potential of Kefir Grains; Unveiling the In Vitro Antibacterial, Antifungal, and Wound Healing Activities. Molecules, 27(6), 2016. https://doi.org/10.3390/molecules27062016

